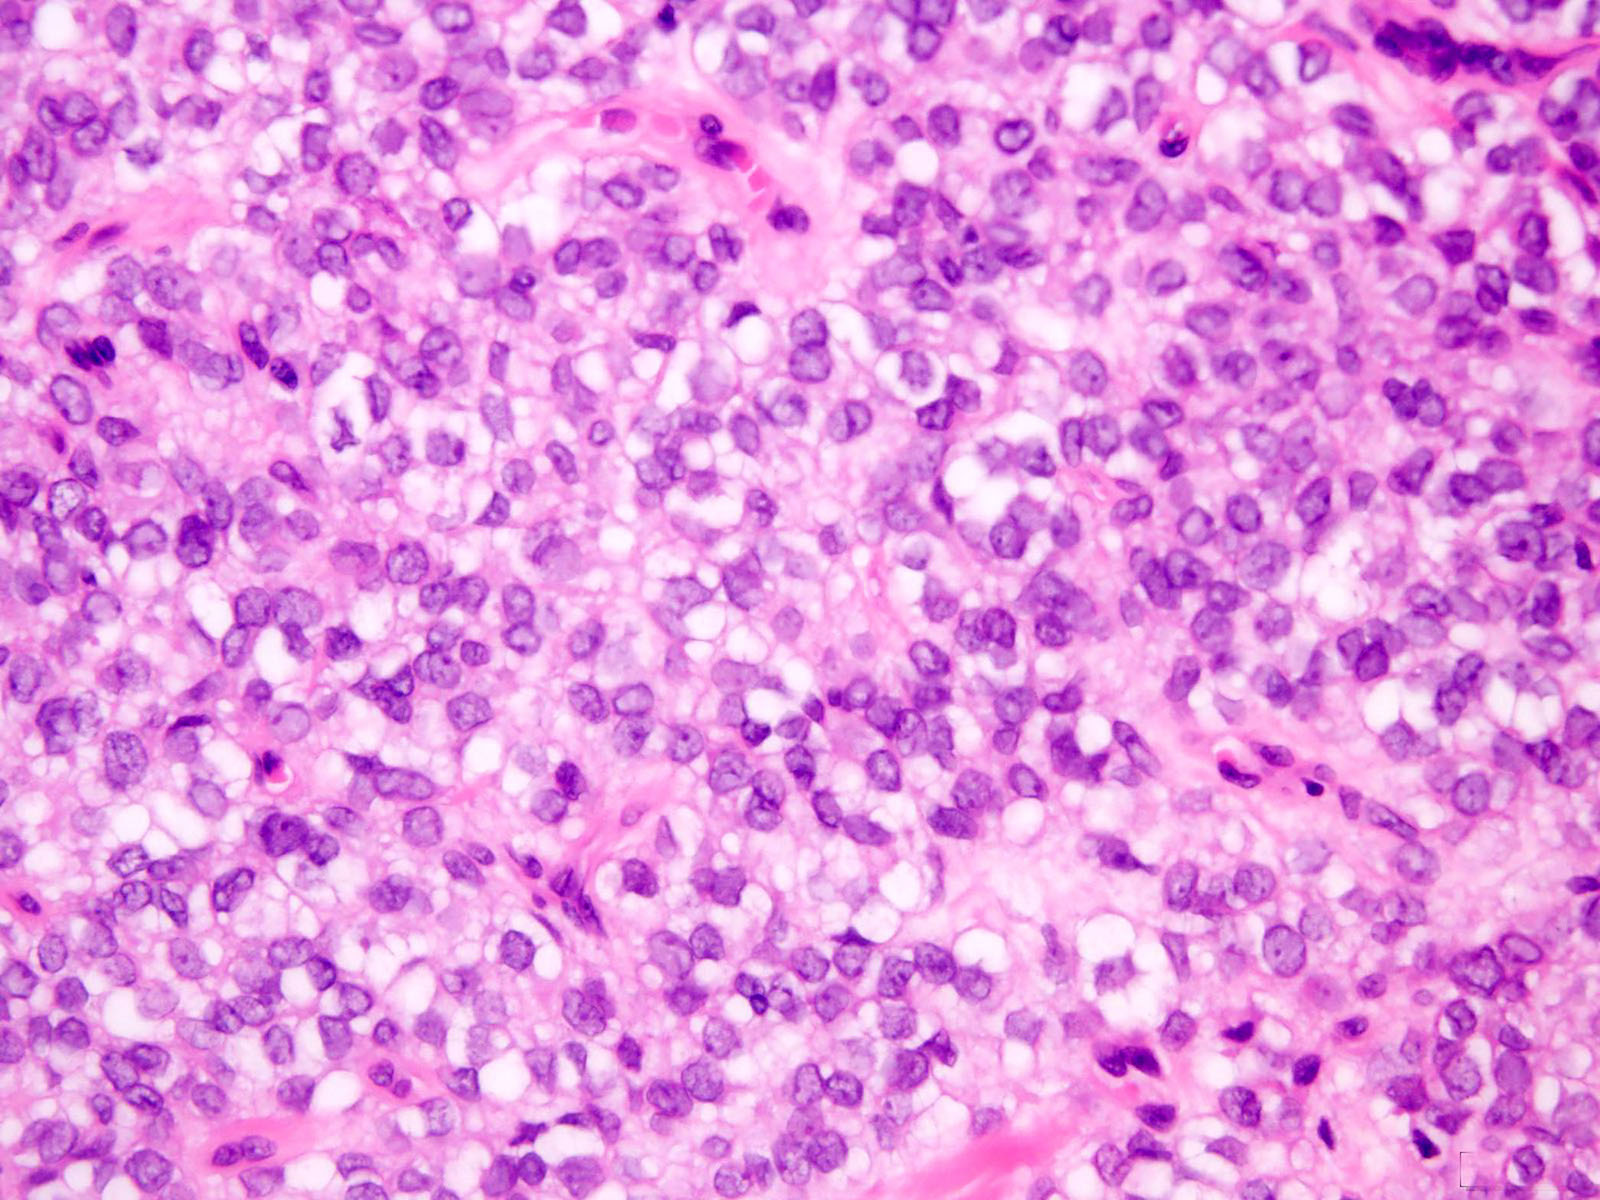

Table of Contents
Definition / general | Essential features | Terminology | ICD coding | Epidemiology | Sites | Pathophysiology | Etiology | Clinical features | Diagnosis | Radiology description | Radiology images | Prognostic factors | Case reports | Treatment | Gross description | Gross images | Microscopic (histologic) description | Microscopic (histologic) images | Cytology description | Positive stains | Negative stains | Electron microscopy description | Molecular / cytogenetics description | Molecular / cytogenetics images | Sample pathology report | Differential diagnosis | Board review style question #1 | Board review style answer #1 | Board review style question #2 | Board review style answer #2Cite this page: Alexiev BA, Laskin WB. Myoepithelioma / myoepithelial carcinoma / mixed tumor. PathologyOutlines.com website. https://www.pathologyoutlines.com/topic/softtissuemyoepithelialca.html. Accessed April 18th, 2024.
Definition / general
- Myoepithelioma, myoepithelial carcinoma and mixed tumor of soft tissue are a group of uncommon neoplasms that share morphological, immunophenotypic and genetic features with their counterparts in salivary gland and skin
Essential features
- Trabecular, reticular, nested or solid growth of variably spindled or epithelioid cells
- Frequent myxoid or hyalinized stroma
- Mixed tumors show ductal differentiation
- Myoepithelial carcinoma shows moderate to severe nuclear atypia, increased mitotic activity and necrosis
- Positivity for S100, EMA, keratin or GFAP
Terminology
- Not recommended: parachordoma
ICD coding
- ICD-O:
- ICD-11: 2F7C & XH3CQ8 - Neoplasms of uncertain behavior of connective or other soft tissue and myoepithelioma
Epidemiology
- Equal distribution between the sexes and a wide age range (median age: 40) (Am J Surg Pathol 1997;21:13, Am J Surg Pathol 2003;27:1183, Am J Surg Pathol 2007;31:1813)
- About 20% of tumors arise in the pediatric population
- Myoepithelial carcinoma seems to be disproportionately common among children (Am J Surg Pathol 2007;31:1813)
Sites
- Most myoepithelial tumors of soft tissue arise on the limbs and limb girdles (Am J Surg Pathol 2003;27:1183, Am J Surg Pathol 2007;31:1813, Genes Chromosomes Cancer 2010;49:1114)
- Others arise on the trunk and the head and neck (Am J Surg Pathol 2003;27:1183)
- Rarely, tumors arise in bone, visceral organs or skin (Genes Chromosomes Cancer 2010;49:1114, Am J Surg Pathol 2013;37:960, Mod Pathol 2011;24:1444)
Pathophysiology
- Some cases are driven by fusions genes (see Molecular / cytogenetics description)
Etiology
- Tumors appear to be sporadic and of unknown etiology
Clinical features
- Myoepithelioma usually presents as a painless nodule of variable size and gradually progressing growth that generally causes no clinical symptomatology (Medicine (Baltimore) 2018;97:e11209, Case Rep Pathol 2020;2020:3747013)
Diagnosis
- Tissue sampling is the gold standard for a definitive diagnosis
- Up to 45% of myoepithelial tumors arising in skin, soft tissue and bone harbor EWSR1 gene rearrangement (and rarely alternate FUS rearrangement) (Genes Chromosomes Cancer 2010;49:1114, Head Neck Pathol 2015;9:32)
Radiology description
- Computed tomography (CT) and magnetic resonance imaging (MRI) show well circumscribed lobulated tumor with heterogenous moderate enhancement (Medicine (Baltimore) 2018;97:e11209)
- 18F-FDG PET shows increased 18F-FDG accumulation (AJR Am J Roentgenol 2006;186:270)
Prognostic factors
- Although the majority of morphologically benign myoepithelial neoplasms of soft tissue behave in a benign fashion, there is an approximate 20% risk for local recurrence (Am J Surg Pathol 2003;27:1183)
- Distant metastasis of morphologically benign myoepithelial neoplasms is rare (Am J Surg Pathol 2003;27:1183)
- Myoepithelial carcinomas show more aggressive behavior, with a recurrence rate of 39 - 42% and distant metastasis in 32 - 52% of affected patients (Head Neck Pathol 2015;9:32)
- Common sites of metastasis include lungs, lymph nodes, bone and soft tissue (Am J Surg Pathol 2003;27:1183, Am J Surg Pathol 2007;31:1813)
Case reports
- 4 year old girl and 6 year old girl with molecularly confirmed primary renal myoepithelial carcinoma (Am J Surg Pathol 2016;40:386)
- 36 year old woman with a molecularly confirmed myoepithelioma of the metatarsal bone (Pathol Int 2019;69:42)
- 40 year old man with a molecularly confirmed myoepithelial carcinoma with a rhabdoid morphology arising in the neck (Head Neck Pathol 2015;9:273)
- 45 year old woman with a molecularly confirmed soft tissue myoepithelial carcinoma of the abdominal wall diagnosed on fine needle aspirate (Diagn Cytopathol 2015;43:421)
- 54 year old man with molecularly confirmed myoepithelioma arising in the sacrum (Histopathology 2014;65:917)
Treatment
- Mainstay of management of localized soft tissue myoepithelioma is surgical resection with clear margins, with pre / postoperative radiation of malignant tumors (Med Oncol 2019;37:13, Am J Clin Oncol 2018;41:357)
Gross description
- Most benign myoepithelial tumors are grossly nodular and well circumscribed (Am J Surg Pathol 2003;27:1183)
- Malignant tumors typically have infiltrative margins
- Cut surface ranges from gelatinous and glistening to firm and fleshy (Am J Surg Pathol 2003;27:1183)
Microscopic (histologic) description
- Wide range of cytologic and architectural features, both within a given lesion and between different tumors
- Though often well circumscribed grossly, both benign and malignant tumors are unencapsulated and frequently have infiltrative margins
- Multinodular or lobular growth (Am J Surg Pathol 2003;27:1183)
- Spindled, ovoid, plasmacytoid or rhabdoid cells with eosinophilic or clear cytoplasm (Am J Surg Pathol 2003;27:1183, Head Neck Pathol 2015;9:273)
- Other morphologic appearances include tumor cells with copious vacuolated cytoplasm (formerly identified in so called parachordoma) (Head Neck Pathol 2015;9:32)
- Nuclei are monomorphic, ovoid or round, with minimal atypia; mitotic activity is variable (Am J Surg Pathol 2003;27:1183)
- Nuclear pleomorphism, macronucleoli and necrosis tend to be associated with malignancy (Am J Surg Pathol 2003;27:1183)
- Mixed tumors contain ductal elements (Am J Surg Pathol 2003;27:1183)
- Metaplastic differentiation may include bone, cartilage, squamous epithelium or adipocytes (Am J Surg Pathol 2003;27:1183)
- Variably myxoid, hyalinized or chondroid stroma (Head Neck Pathol 2015;9:32)
- Myoepithelial tumors with EWSR1-POUSF1 fusion demonstrate distinctive morphological features (nested growth of epithelioid cells with clear cytoplasm) (Head Neck Pathol 2015;9:32)
- Myoepithelial carcinomas have moderate to severe atypia with vesicular nuclei and prominent nucleoli, often together with a high mitotic count and necrosis (Am J Surg Pathol 2003;27:1183, Am J Surg Pathol 2007;31:1813, Head Neck Pathol 2015;9:32)
- There are no clearly defined or validated criteria for grading of myoepithelial carcinoma (Head Neck Pathol 2015;9:32)
- Cytologic atypia has been shown to be the sole predictor of aggressive behavior in soft tissue (Am J Surg Pathol 2003;27:1183)
- Morphologic variants:
- Cutaneous syncytial myoepithelioma
- Microscopically, tumors show a solid sheet-like growth of uniformly sized ovoid to spindled or histiocytoid cells with palely eosinophilic syncytial cytoplasm (Am J Surg Pathol 2013;37:710)
- Cutaneous syncytial myoepithelioma
- Mixed tumor
- Tubuloductal differentiation, appearing similar to their salivary gland counterparts (Head Neck Pathol 2015;9:32)
- Myoepithelial carcinomas with round cell undifferentiated component
- Round cell undifferentiated component is observed in up to 10% of myoepithelial carcinomas that arise in pediatric patients (Am J Surg Pathol 2013;37:710)
Microscopic (histologic) images
Cytology description
- Moderately cellular smears showing loosely arranged clusters, sheets, isolated cells, rosette-like arrangement with fibrillary material within (Cytojournal 2017;14:14)
- Round to oval, spindle, epithelioid and plasmacytoid cells in myxoid background (Diagn Cytopathol 2016;44:152)
- Bland uniform, round to ovoid nuclei with finely distributed chromatin and eosinophilic or pale cytoplasm (Diagn Cytopathol 2016;44:152)
Positive stains
- Keratin AE1 / AE3, EMA, S100, calponin (Am J Surg Pathol 2003;27:1183, Am J Surg Pathol 2013;37:710, Head Neck Pathol 2015;9:273)
- GFAP, smooth muscle actin, SOX10, p63 tend to be more variable (Am J Surg Pathol 2003;27:1183, Head Neck Pathol 2015;9:273)
- Cutaneous syncytial myoepithelioma has a distinct immunophenotype of EMA and S100 positivity but infrequent cytokeratin staining (Am J Surg Pathol 2013;37:710)
- PLAG1 immunostaining is positive in 58 - 100% of mixed tumors but is negative in myoepitheliomas lacking ductal differentiation (Head Neck Pathol 2015;9:32)
- A panel including keratin AE1 / AE3, EMA, S100 and GFAP will identify myoepithelial differentiation in the majority of cases (Head Neck Pathol 2015;9:32)
Negative stains
- CD34, ERG
- SMARCB1 / INI1 expression is lost in a subset of myoepitheliomas and myoepithelial carcinomas (Am J Surg Pathol 2007;31:1813, Am J Surg Pathol 2009;33:542)
Electron microscopy description
- Intercellular desmosome-like junctions and basal lamina (Pathol Int 2005;55:510)
- Subplasmalemmal densities and cytoplasmic myofilaments (Pathology 2002;34:451)
Molecular / cytogenetics description
- EWSR1 is most commonly rearranged, followed by FUS (Genes Chromosomes Cancer 2010;49:1114, Genes Chromosomes Cancer 2015;54:267, Genes Chromosomes Cancer 2020;59:348)
- Fusion partners include: ATF1, KLF15, KLF17, PBX1, PBX3, POU5F1, VGLL1 and ZNF444 (Hum Pathol 2012;43:764, Am J Surg Pathol 2016;40:386, Genes Chromosomes Cancer 2008;47:558, Genes Chromosomes Cancer 2015;54:63, Genes Chromosomes Cancer 2010;49:1114, Histopathology 2014;65:917, Genes Chromosomes Cancer 2020;59:249, Genes Chromosomes Cancer 2009;48:1051)
- EWSR1-POU5F1 fusions are associated with malignant myoepithelial tumor with nested epithelioid growth and clear cell morphology (Genes Chromosomes Cancer 2020;59:348)
- Myoepithelial tumors with EWSR1-PBX1/3 fusions are often benign and associated with bland spindle cell and sclerotic morphology (Genes Chromosomes Cancer 2020;59:348)
- FUS-KLF17 fusions are associated with chordoma-like morphology (Genes Chromosomes Cancer 2020;59:348)
- Superficial tumors and those with ductal differentiation tend to genetically approximate mixed tumors / pleomorphic adenomas of salivary gland with PLAG1 rearrangement (Genes Chromosomes Cancer 2013;52:675)
- Novel SS18-POU5F1 has been reported in a malignant round cell neoplasm with myoepithelial phenotype (Histopathology 2020;77:681)
Sample pathology report
- Left leg, biopsy:
- Myoepithelioma (see comment)
- Comment: The neoplasm is composed of epithelioid and spindle cells with eosinophilic cytoplasm arranged in anastomosing cords and nests. Nuclei are monomorphic, ovoid or round, with minimal atypia. Interspersed between the cells there is abundant myxohyaline stroma. Occasional mitotic figures are identified (2 mitoses/10 high power fields). The cells are positive for SMA, S100, keratin AE1 / AE3 and GFAP. The findings support the above diagnosis. Although the majority of morphologically benign myoepithelial neoplasms of soft tissue behave in a benign fashion, there is an approximate 20% risk for local recurrence.
Differential diagnosis
- Extraskeletal myxoid chondrosarcoma:
- INSM1 expression in 90% of cases; however, INSM1 expression was also observed in a small subset (1 of 20) of soft tissue myoepithelioma (Mod Pathol 2018;31:744)
- Negative epithelial markers (AE1 / AE3, CAM5.2, EMA) (Hum Pathol 2001;32:1116)
- Characteristic translocations, typically t(9;22)(q22;q12.2), fusing EWSR1 to NR4A3 genes (Cancer 2008;113:3364)
- Smaller proportion of cases show NR4A3 fused to other gene partners including TAF15, TCF12 and TFG (Hum Pathol 2014;45:1084)
- Ossifying fibromyxoid tumor:
- Most cases show a peripheral shell of lamellar bone (Genes Chromosomes Cancer 2014;53:183)
- Desmin expression in 70% of cases (Genes Chromosomes Cancer 2014;53:183)
- PHF1 gene rearrangement has been observed in 80% of OFMTs, including benign, atypical and malignant subtypes, with fusion to EP400 in 44% of cases (Arch Pathol Lab Med 2016;140:371, Hum Pathol 2013;44:2603)
- ZC3H7B-BCOR and MEAF6-PHF1 fusions occur predominantly in S100 negative and malignant OFMT (Genes Chromosomes Cancer 2014;53:183)
- Soft tissue chordoma:
- Brachyury expression (Am J Surg Pathol 2008;32:572, Am J Surg Pathol 2013;37:719)
- No EWSR1 rearrangement
- Myxofibrosarcoma, epithelioid variant:
- c-MET overexpression (Diagn Pathol 2018;13:56)
- Negative for S100, pankeratin and SMA (Am J Surg Pathol 2007;31:99, World J Surg Oncol 2012;10:245)
- No EWSR1 rearrangement
- Myxoid leiomyosarcoma:
- HMGA2, h-caldesmon and desmin expression (Hum Pathol 2017;59:139, Hum Pathol 1999;30:392, Am J Surg Pathol 2000;24:927)
- Negative for S100 and GFAP (Hum Pathol 1991;22:569, Histochem J 1983;15:691)
- No EWSR1 rearrangement
- Malignant melanoma:
- HMB45 expression (J Biomed Sci 2010;17:87)
- Epithelial markers negative in majority of cases; however, pankeratin expression was observed in undifferentiated / dedifferentiated melanoma (Arch Pathol Lab Med 1987;111:447, Am J Surg Pathol 2016;40:181)
- BRAF (V600E) mutation (Am J Surg Pathol 2016;40:181)
- Mucinous / colloid carcinoma:
- Primary cutaneous mucinous carcinoma of the skin express ER and GCDFP-15 (Am J Dermatopathol 2004;26:353)
- CDX2, SATB2 and nuclear beta catenin expression is seen in metastasis from lower gastrointestinal (GI) tract adenocarcinoma (Am J Surg Pathol 2011;35:1830)
- PAX8 and CK7 expression is seen in metastasis from gynecologic adenocarcinoma (Am J Surg Pathol 2011;35:1830)
- ER, GATA3, WT1 and CK7 expression is seen in metastasis from breast carcinoma (Am J Surg Pathol 2011;35:1830)
- Upper GI tract adenocarcinomas are frequently positive for CK7 and MUC6 (Am J Surg Pathol 2011;35:1830)
- Lung mucinous adenocarcinomas are frequently positive for CK7 and MUC1
- S100 negative (Am J Dermatopathol 2004;26:353)
- KRAS mutation (Cancers (Basel) 2018;10:108)
- No EWSR1 rearrangement
- Epithelioid schwannoma:
- Majority of tumors are negative for keratin; focal keratin expression in rare cases has been described (Diagn Pathol 2017;12:11, Am J Surg Pathol 2017;41:1013)
- EMA and SMA negative (Diagn Pathol 2017;12:11, Am J Surg Pathol 2017;41:1013)
- Loss of SMARCB1 / INI1 in approximately 40% of cases (Am J Surg Pathol 2017;41:1013)
- No EWSR1 rearrangement
- Epithelioid malignant peripheral nerve sheath tumor (MPNST):
- 67% show SMARCB1 / INI1 loss (Am J Surg Pathol 2015;39:673)
- Majority of tumors are negative for keratin and EMA; focal keratin expression was observed in 5% of cases (Am J Surg Pathol 2015;39:673, Am J Surg Pathol 2017;41:1013)
- Loss of H3K27me3 expression has good sensitivity and robust specificity for the diagnosis of MPNST; however, H3K27me3 expression is retained in epithelioid MPNST (Am J Surg Pathol 2016;40:479, Histopathology 2017;70:385)
Board review style question #1
The most common gene rearranged in myoepithelial tumors is
- EWSR1
- FUS
- SS18
- ZNF444
Board review style answer #1
Board review style question #2
A 45 year old man presented with a left thigh mass. Hematoxylin-eosin stains demonstrated a nested and trabecular growth of small to medium sized spindled to epithelioid cells with uniform, round to ovoid nuclei and eosinophilic or pale cytoplasm in myxoid background. Occasional mitotic figures were identified (2 mitoses/10 high power fields). Immunohistochemical stains for S100, keratin AE1 / AE3, GFAP and calponin (focal) were positive in tumor cells while all of the following were negative: desmin, CD34, ERG and h-caldesmon. SMARCB1 / INI1 expression was preserved. Which of the following is most likely the correct diagnosis?
- Extraskeletal myxoid chondrosarcoma
- Ossifying fibromyxoid tumor
- Metastatic carcinoma
- Epithelioid sarcoma
- Myoepithelioma
Board review style answer #2